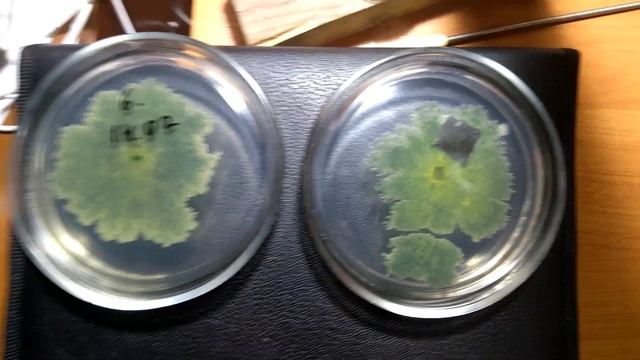
Глобиома Биота Макс смотреть онлайн

Автор / Канал: Домовенок Ремонтович Страница 9

Сочетание Chopper Accademia + Romanza Lana Grossa

Гаснет газовая духовка, система газ контроль, устраняем проблему

Добро пожаловать на канал ТМ «Агротекс»!

Центрально - Черноземный Государственный Заповедник ( часть 3)

Гортензия Сбежавшая невеста

Forged with chrome vanadium steel, high hardness

Plant Spotlight Dendrobium loddigesii
Глобиома Биота Макс

Организация хранения на кухне. Про технику. Повесили тюль. И ещё кое-что))

Обзор дома 110 м2 на участке 8 соток

Кто такие орнитомимы? древние страусы?

Динамические микрофоны МД-47 (1962 г), и МД-45 (1963г).

Создание 3D модели и управляющей программы для станка с ЧПУ

интерьер комнаты в старинном стиле

How to download driver, install in Windows 10 and scan document of printer LaserJet M1132 MFP

Прополка минитрактором

Слива диплоїдна Ренклод альтана

Лён + Фум-лента супер- пупер уплотнение резьбы!!!

Plant of the Week | 'Cotton Candy' Mango

Реализованный проект Лаунж зоны и террасы в Минске

Сварка труб без отрыва за один проход

Ин. Вариегаты. Регресс 21

Металлоискатель "ПИРАТ", Своими руками, СХЕМА

цетус конзу заказ 4
За каждым успешным каналом стоит личность, идея и сотни часов кропотливого труда. Если вы здесь, значит, автор «Домовенок Ремонтович» уже сумел зацепить ваше внимание своим уникальным стилем или подачей. А мы на RUVIDEO позаботились о том, чтобы вы могли изучить весь архив его работ в максимально комфортных условиях — без лишней суеты и преград.
Почему за работами канала «Домовенок Ремонтович» так интересно наблюдать? Всё просто: это честный контент, который находит отклик в сердцах зрителей. На нашем ресурсе вы можете смотреть онлайн все видео любимого автора бесплатно и в хорошем качестве. Нам важно, чтобы вы видели каждую деталь и слышали каждый нюанс, поэтому мы используем только стабильные плееры из открытых источников Rutube.
Следите за новинками канала, пересматривайте старые шедевры и открывайте для себя новые грани творчества «Домовенок Ремонтович». Мы постоянно обновляем ленту, чтобы у вас под рукой всегда были самые свежие выпуски. Никаких сложных регистраций — только вы и творчество, которое вдохновляет. Приятного вам путешествия по миру авторского контента на RUVIDEO!
Видео взято из открытых источников Rutube. Если вы правообладатель, обратитесь к первоисточнику.